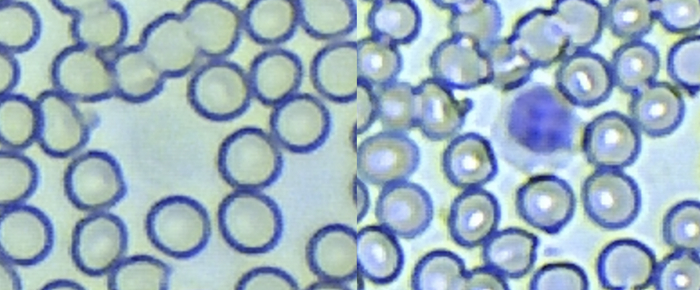

Возникла у меня идея самостоятельно и в домашних условиях сделать анализ крови. Опыта в этом у меня нет (и медицинского образования тоже), но что-то интересное получилось, чем и хочу поделиться.
Погуглив тему, я приобрел микроскоп с 1000-кратным увеличением, краситель по Райту-Гимзе (готовый к применению раствор) и ланцет от глюкометра (штука, которая безболезненно протыкает кожу на пальце).
Посмотрел ролики на YouTube, как сделать мазок, как его красить и приступил к делу.
Приготовить мазок (размазать кровь по предметному стеклу) получилось приемлемо раза с третьего. А вот окраска получилась практически сразу. Я использовал самый простой вариант: капал на подсохший мазок краситель и через пару минут аккуратно смывал обычной водой из крана.
Далее ставил стеклышко на ребро и ждал несколько минут, чтобы оно подсохло. После этого можно смотреть в микроскоп.
Никакого покровного стекла использовать не нужно! Тысячекратное увеличение делается с иммерсионным маслом (у меня прилагался флакончик к микроскопу). Капаем масло прямо на мазок, погружаем в каплю объектив (тот, что для масла! На нем надпись "OIL") и смотрим.
Дальше начинается самое интересное.
Для подсчета лейкоцитарной формулы нужно отыскать сотню лейкоцитов и определить их тип. Вот так у меня выглядит окрашенный мазок под 160-кратным увеличением (уровень увеличения простого школьного микроскопа). Сине-фиолетовые точки - это лейкоциты, остальное - эритроциты.
Под 1000-кратным увеличением хорошо видна структура ядра и цитоплазмы лейкоцитов, и их можно классифицировать.
Обычно в крови всего 5 типов лейкоцитов. Больше всего нейтрофилов (60%), и их определить достаточно легко - ядро разделено на части или изогнуто в форму длинной 'S' или 'C'-образной структуры. Вот примеры нейтрофилов из моей капли крови.
Примерно 30% лейкоцитов - это лимфоциты. Обычно они очень маленькие, с круглым "плотным" ядром и тонким слоем цитоплазмы.
Однако лимфоциты бывают и крупные, с растянутым ядром, что создает проблему, так как их легко перепутать с моноцитами.
Определить моноциты оказалось довольно сложно, и я до сих пор сомневаюсь, правильно ли я их определяю. Это самые крупные клетки с овальной или неправильной формой ядра. Часто у них есть вакуоли (белые пузырьки в цитоплазме). Их примерно 5% в крови. Вот пример, надеюсь, я их не перепутал с лимфоцитами.
И еще пара очень редких (менее 1%), но самых красивых клеток - эозинофилы (с красными зернистыми гранулами в цитоплазме) и базофилы с голубыми:
После подсчета клеток у меня получился вот такой результат:
Нейтрофилы - 48%, лимфоциты - 40%, моноциты - 11%, базофилы - 1%, эозинофилы - 1%.
Попросил GPT-4 интерпретировать этот результат и получил вот такой ответ:
На основе представленных данных можно сделать несколько наблюдений:
Нейтрофилы находятся в нормальном диапазоне.
Лимфоциты несколько повышены, что может быть связано с вирусной инфекцией или некоторыми другими состояниями, такими как хронический стресс или автоиммунные заболевания.
Моноциты повышены, что может указывать на хроническое воспаление, инфекционные заболевания (например, туберкулез, бактериальные эндокардиты), а также на возможные автоиммунные или онкологические процессы.
Эозинофилы и базофилы находятся в пределах нормы.
Такое распределение лейкоцитарной формулы требует дальнейшего клинического анализа с учетом симптомов, анамнеза и других лабораторных данных для точной интерпретации и диагностики.
Подозреваю, что с моноцитами я все-таки ошибся, а вот лимфоциты, скорее всего, действительно повышены. Буду дальше наблюдать и попробую на какое-то время сделать анализ крови ежедневной процедурой.
А еще я увидел, почему лейкоциты - белые кровяные тельца. Вот два снимка до и после окраски крови. Лимфоцит до окраски действительно белый (практически невидим).